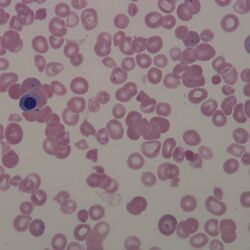

Agglutination
From haematologyetc.co.uk
Derivation: From latin “fasten with glue”
Description
Erythrocytes linked together to form irregular clumps of varying size.
Appearance: The key point is that the red cell form group that are very irregular rather than linear. In many cases they will include cells that have been damaged by the underlying immunological process causing agglutination (shown in the cartoon image as a spherocyte and irregularly contracted cell with the agglutinated group). A small image from a clinical case is shown for comparison, but note that agglutinates may be much bigger in many cases.
Significance
Agglutinates arise when antibodies attach to antigens on the membranes of adjacent red cells linking them together. The most common cause is "cold-reactive" IgM antibodies which do not cause overt symptoms. However, in some cases the effects may be clinically significant since antibodies may activate complement causing haemolysis, or the agglutinated cells can cause occlusion of small blood vessels in the cold (acrocyanosis). The clumped cells will sediment more rapidly leading to a raised erythrocyte sedimentation rate (ESR). Finally, the antibodies that cause cold agglutination may indicate an underlying malignancy (particularly lymphoma), or by acute infection.
Pitfalls
Be sure to examine at the correct part of the blood film since cells often group together in thicker parts of the blood film - in true agglutination this effect will be seen within the normal viewing region of the film; also be careful to distinguish the appearance from rouleaux. If agglutination and rouleaux co-exist, then it is important to look for the much more irregular clumping that characterises agglutination. A specific cold-reactive IgG antibody (Donath Landsteiner antibody) causes the clinical disorder Paroxysmal Cold Haemoglobinuria (PCH). It is very important to recognise this condition which carries greater clinical significance (see images for associated features).
1. Causes
| Primary Causes |
|---|
| Monoclonal IgM frequently recognising blood group "I", peak incidence in the elderly, but may arise from the 5th decade |
| Secondary Causes (transient) |
| Commonly: Mycoplasma pneumoniae or Epstein Barr virus |
| Other viral including: influenza, HIV, CMV, rubella |
| Non-viral: bacterial endocarditis, syphilis, malaria |
| Secondary Causes (sustained) |
| Commonly: Lymphoma, Waldenstroms macroglobulinaemia, CLL |
| Rarely: Non-haematological malignancy |
| Donath Landsteiner antibody |
| Most commonly seen in chlidren, this IgG antibody recognises the P antigen - the clinical presentation differs: cold haemaglutinin disease (CHAD) |
| Syphilis (congenital or tertiary syphilis classical but now uncommon) |
| Viral: measles, mumps, influenza A, adenovirus, CMV, EBV and post-vaccination |
| Bacterial: H.influenza, Mycoplasma pneumoniae |
| Chronic idiopathic |
Clinical Examples
Clinical Image 1: A low power image shows how the disease is first detected – the agglutinates cause a very irregular distribution of cells that on closer examination can be seen to comprise erythrocytes in irregular clumps. In severe cases these changes can be detected without the need for microscopy. Clinical condition: cold haemagglutinin disease (CHAD).
Clinical Image 2: Several irregular groups of cells are shown, these are very different from the linear structures of rouleaux and can be seen to include dense damaged cells both within the agglutinates and circulating separately. Clinical condition: cold haemagglutinin disease (CHAD)
Clinical Image 3: Agglutinates are clearly shown, and are comprised of normal and damaged erythrocytes. In this case the additional presence of erythrophagocytosis by neutrophils is present – this is characteristic of this condition. Clinical condition: paroxysmal haemoglobinuria (PCH) (see separate discussion in neutrophil section).
Pathobiology
Agglutination is caused by antibodies that link adjacent cells and hence are generally caused by antibodies that are polyvalent (IgM or less commonly IgA subclass). Most commonly the antibodies recognise red cell antigens of "I" or "i" groups. Since these antibodies generally only bind antigen at temperatures below normal body temperature, their effects may be reversed if the sample is heated and the blood smear is made on a warmed slide. Cold reactive IgG antibodies may also cause agglutination, but tend to have a different clinical presentation dominated by haemolytic symptoms (Paroxysmal Cold Haemoglobinuria).